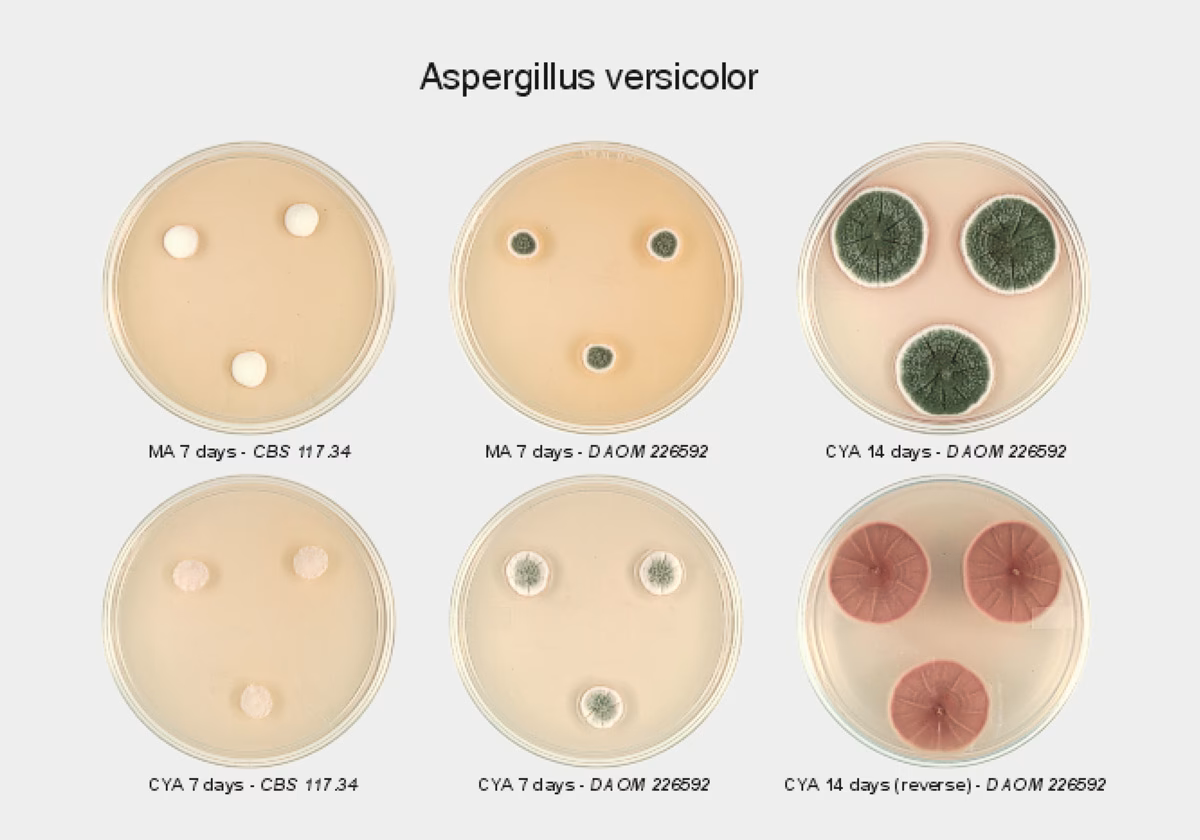
¿Cuál es el comportamiento de los hongos como alérgenos?

08/05/2025
Los hongos son un reino de seres vivos fascinante y omnipresente, desempeñando roles cruciales en nuestros ecosistemas, desde la descomposición de materia orgánica hasta su uso en la gastronomía y la medicina. Sin embargo, cuando proliferan en lugares no deseados, pueden convertirse en un problema serio, actuando como contaminantes biológicos. Comprender qué son, cómo identificarlos y los riesgos que conllevan es fundamental para mantener un entorno saludable y seguro, tanto en nuestros hogares como en ambientes controlados como los laboratorios.

¿Qué Define a un Hongo como Contaminante?
Un hongo se considera contaminante cuando su crecimiento ocurre en un sustrato o ambiente donde no es deseado, pudiendo causar deterioro material, problemas de salud o la alteración de procesos industriales o de investigación. Comúnmente los asociamos con el moho que crece en alimentos o en paredes húmedas, pero su alcance es mucho mayor. Estos organismos se reproducen mediante esporas, partículas microscópicas que viajan por el aire y que, al encontrar condiciones adecuadas de humedad, temperatura y nutrientes, germinan y forman nuevas colonias (micelios).
Las condiciones que favorecen su aparición son, principalmente:
- Humedad elevada: Es el factor más crítico. Fugas de agua, condensación o mala ventilación son caldos de cultivo perfectos.
- Temperatura moderada: La mayoría de los hongos contaminantes prosperan en rangos de temperatura confortables para los humanos.
- Presencia de nutrientes: Materiales orgánicos como la madera, el papel, el cartón, los tejidos de algodón, el polvo y la suciedad sirven de alimento para ellos.
- Oxígeno: Como organismos aerobios, necesitan oxígeno para su metabolismo.
Identificación Precisa: Del Ojo Desnudo al Microscopio
La identificación de hongos contaminantes es un proceso que varía en complejidad. A nivel doméstico, la primera señal suele ser visual: manchas de colores diversos (negro, verde, blanco, anaranjado) en superficies, a menudo acompañadas de un olor característico a humedad o a tierra mojada. Sin embargo, esta identificación visual es meramente superficial y no permite conocer la especie ni su potencial peligrosidad.

Para una identificación científica y rigurosa, es indispensable el trabajo en laboratorio. Como bien se indica en los procedimientos estandarizados, es necesario cultivar el hongo para poder estudiarlo. Este proceso implica:
- Toma de Muestras: Se recolecta una pequeña muestra del hongo visible o del aire del lugar afectado mediante hisopos estériles o placas de sedimentación.
- Siembra en Medio de Cultivo: La muestra se transfiere a un medio de cultivo selectivo en una placa de Petri. Estos medios están diseñados para favorecer el crecimiento de hongos sobre el de bacterias. Los más utilizados, como el Agar Sabouraud Dextrosa (SDA), tienen una alta concentración de azúcar y un pH ligeramente ácido, condiciones ideales para el desarrollo fúngico masivo.
- Incubación: Las placas se incuban a una temperatura controlada durante varios días, permitiendo que las esporas germinen y formen colonias visibles.
- Análisis Macroscópico y Microscópico: Una vez desarrolladas, se analizan las características de las colonias (color, textura, velocidad de crecimiento) y, fundamentalmente, se observa una muestra bajo el microscopio para identificar las estructuras reproductivas (conidióforos, esporangios) que son clave para la clasificación de la especie.
Impacto en la Salud y el Medio Ambiente
La presencia de hongos contaminantes no es solo un problema estético. Su impacto puede ser significativo:
Riesgos para la Salud Humana
Los hongos pueden afectar la salud de tres maneras principales:
- Alergias: Las esporas y fragmentos de micelio son potentes alérgenos. La inhalación continua puede desencadenar o agravar síntomas como rinitis, asma, conjuntivitis y dermatitis en personas sensibles.
- Toxicidad: Ciertas especies de hongos, como Stachybotrys chartarum (el famoso "moho negro tóxico") o algunas cepas de Aspergillus, pueden producir compuestos volátiles y micotoxinas. Estas sustancias tóxicas pueden causar, tras una exposición prolongada, problemas neurológicos, irritación de las vías respiratorias y otros efectos sistémicos graves.
- Infecciones (Micosis): En personas con el sistema inmunitario debilitado (inmunodeprimidas), las esporas de hongos oportunistas como Aspergillus fumigatus pueden causar infecciones pulmonares graves y diseminadas.
Impacto Ambiental y Material
Más allá de la salud, los hongos son agentes de biodeterioro. Al alimentarse de materiales orgánicos, degradan estructuras de madera, papel de paredes, libros, obras de arte y textiles, causando daños materiales y económicos considerables. En la industria alimentaria, son una de las principales causas de pérdida de cosechas y deterioro de alimentos procesados.
Tabla Comparativa de Hongos Contaminantes Comunes
| Hongo | Aspecto Común | Ubicación Frecuente | Riesgo Principal |
|---|---|---|---|
| Aspergillus | Colonias de color verde, amarillo o negro, de aspecto pulverulento. | Paredes, sistemas de ventilación, polvo, alimentos (cereales, especias). | Alergias, producción de micotoxinas (aflatoxinas), infecciones (aspergilosis). |
| Penicillium | Moho de color azul o verde, aterciopelado. | Alimentos (frutas, pan, quesos), paredes húmedas, colchones. | Alergias, deterioro de alimentos. Algunas especies producen micotoxinas. |
| Cladosporium | Manchas de color verde oliva a negro. | Marcos de ventanas, tejidos, superficies de baños y cocinas. Muy común en exteriores. | Principalmente alergias (fiebre del heno, asma). |
| Stachybotrys chartarum | Moho negro o verdoso oscuro, de aspecto viscoso o gelatinoso. | Materiales con alto contenido de celulosa y muy dañados por el agua (yeso, cartón). | Producción de potentes micotoxinas, asociadas a problemas respiratorios severos. |
Gestión y Eliminación Segura
La eliminación de hongos contaminantes debe realizarse con precaución. Para pequeñas áreas en el hogar, se pueden usar soluciones de limpieza específicas o vinagre, siempre utilizando equipo de protección (mascarilla, guantes, gafas). Sin embargo, la clave es solucionar el problema de humedad subyacente.
En el contexto de un laboratorio, donde se manipulan cultivos de hongos potencialmente patógenos, la seguridad es primordial. Los protocolos son estrictos para evitar la contaminación del personal y del medio ambiente. Los cultivos deben ser manejados en cabinas de seguridad biológica, y una vez finalizado su estudio, deben ser sellados con cinta adhesiva y esterilizados en un autoclave. Este equipo utiliza vapor a alta presión y temperatura para destruir todos los microorganismos. Posteriormente, se desechan como residuos biológicos de riesgo (grupo III) en contenedores especiales, garantizando una eliminación segura y definitiva.

Preguntas Frecuentes (FAQ)
¿Todo el moho negro es tóxico?
No. Existen muchas especies de hongos que son de color negro y no todas producen micotoxinas peligrosas. Sin embargo, dado que es imposible diferenciar a simple vista, cualquier crecimiento de moho en interiores debe tratarse como un riesgo potencial y eliminarse adecuadamente.
¿Puedo eliminar una gran infestación de moho por mi cuenta?
Si la zona afectada es superior a un metro cuadrado, o si sospechas que el moho está en los sistemas de ventilación, se recomienda encarecidamente contactar a profesionales en remediación de moho. Ellos cuentan con el equipo y conocimiento para eliminarlo de forma segura y completa sin dispersar las esporas por el resto del edificio.

¿Qué significa que un medio de cultivo sea "selectivo"?
Un medio selectivo es aquel que contiene ingredientes que inhiben el crecimiento de ciertos tipos de microorganismos mientras promueven el de otros. En el caso de los hongos, los medios suelen contener antibióticos para impedir el crecimiento de bacterias, que de otro modo competirían por los nutrientes y dificultarían el aislamiento y estudio del hongo de interés.
En conclusión, los hongos contaminantes son un desafío ambiental y sanitario que requiere atención y conocimiento. Desde la identificación visual en el hogar hasta el riguroso análisis en el laboratorio, entender su biología y los métodos para su control es esencial para proteger nuestra salud, nuestros bienes y la integridad de la investigación científica.
Si quieres conocer otros artículos parecidos a Hongos Contaminantes: Guía de Identificación y Riesgos puedes visitar la categoría Ecología.